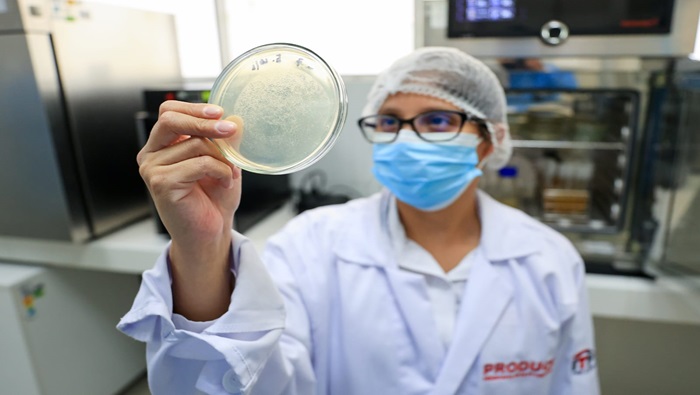
FOTO
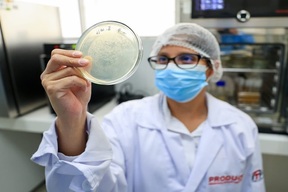

Produce: Crean Unidad Técnica Agroindustrial Junín para potenciar el desarrollo productivo regional
Nota de prensaSu puesta en marcha promoverá la innovación en la agroindustria y generará mayores oportunidades de crecimiento para las MYPE.

21 de febrero de 2026 - 8:04 a. m.
El Instituto Tecnológico de la Producción (ITP), organismo público adscrito al Ministerio de la Producción, aprobó la creación de la Unidad Técnica Agroindustrial Junín, que fortalecerá la innovación, la transferencia tecnológica y el desarrollo productivo de la cadena agroindustrial en la mencionada región.
La UT estará adscrita al Centro de Innovación Productiva y Transferencia Tecnológica Agroindustrial Oxapampa y tendrá como ámbito de acción el departamento de Junín, ampliando así la cobertura territorial de los servicios especializados de la red CITE.
Esta nueva Unidad Técnica, creada oficialmente mediante la Resolución Ejecutiva N.° 000039-2026-ITP/DE, brindará asistencia técnica, capacitación especializada, transferencia tecnológica y acompañamiento a las unidades productivas agroindustriales, con el objetivo de mejorar su productividad, calidad, capacidad de innovación y competitividad en los mercados nacional e internacional.
Entre sus principales líneas de acción destacan la optimización de procesos productivos, el desarrollo de productos con mayor valor agregado, la promoción de la investigación, desarrollo e innovación (I+D+i), así como el impulso al emprendimiento y la articulación con actores estratégicos del ecosistema productivo regional.
Con esta intervención, el ITP red CITE continúa su compromiso de acercar servicios tecnológicos de calidad a más regiones del país y contribuir al desarrollo económico sostenible del Perú. La puesta en marcha de la Unidad Técnica Agroindustrial Junín representa un paso estratégico para fortalecer el ecosistema productivo regional, promover la innovación en la agroindustria y generar mayores oportunidades de crecimiento para las mypes.
Dato
Durante el 2025, Produce mediante el ITP y su red CITE ubicados en diversas regiones del país, logró atender a más de 14 690 clientes alcanzado más de 100 470 servicios especializados.
Entre los servicios más solicitados se encuentran: ensayos de laboratorio, soporte productivo, capacitación, información tecnológica especializada, asistencia técnica, diseño y desarrollo de productos, entre otros.